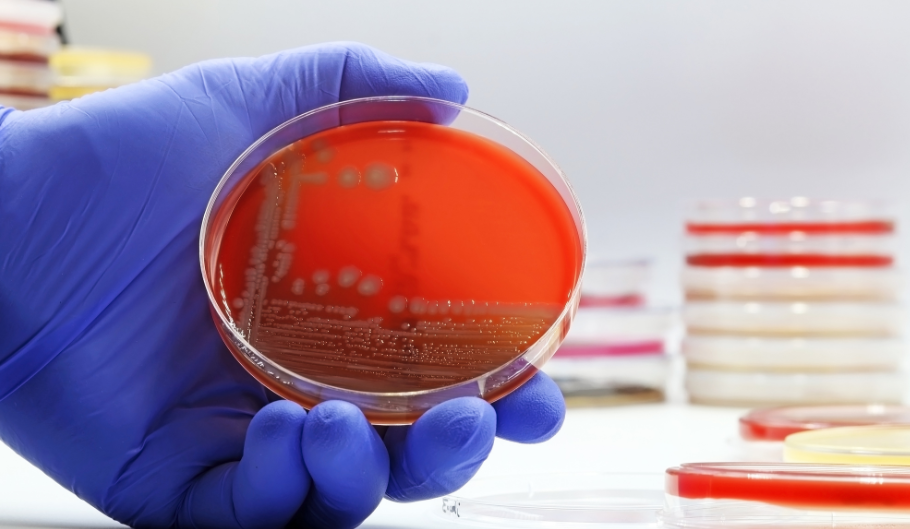
Cosa non si deve mangiare se si soffre di Escheria Coli

Articolo Blog
Cosa non si deve mangiare se si soffre di Escheria Coli
L’infezione da Escherichia coli è una delle più comuni cause di disturbi gastrointestinali, con sintomi che possono variare da lievi fastidi a forme più gravi, come crampi addominali, diarrea, febbre e, nei casi più critici, complicazioni renali. Questo batterio, normalmente presente nell’intestino, può diventare patogeno quando si ingeriscono cibi o bevande contaminate.
Quando si contrae un’infezione da Escherichia coli, l’alimentazione gioca un ruolo cruciale nel favorire il recupero o, al contrario, nell’aggravare i sintomi. Alcuni alimenti possono infatti peggiorare l’infiammazione intestinale e prolungare il tempo di guarigione. È quindi fondamentale sapere cosa evitare per non sovraccaricare il sistema digestivo e favorire una ripresa più rapida.
Uno dei principali alimenti da escludere è la carne cruda o poco cotta. L’Escherichia coli è spesso associata a carne contaminata, in particolare carne macinata e hamburger non completamente cotti. Questo batterio può resistere alla superficie della carne e, se la cottura non raggiunge temperature elevate, può sopravvivere e continuare a proliferare nell’organismo. È quindi essenziale cuocere sempre la carne ad almeno 70°C per eliminare ogni rischio di contaminazione.
Anche i latticini non pastorizzati rientrano tra gli alimenti da evitare. Latte, formaggi freschi e yogurt prodotti con latte crudo possono contenere Escherichia coli, così come altri batteri pericolosi. Il consumo di questi prodotti può aggravare i sintomi dell’infezione, provocando ulteriori episodi di diarrea e crampi addominali. È sempre consigliato, quindi, scegliere latticini pastorizzati, che garantiscono un livello di sicurezza maggiore.
Le verdure crude, se non adeguatamente lavate e disinfettate, rappresentano un altro rischio significativo. Insalate, spinaci, sedano, pomodori e altri ortaggi possono venire a contatto con acqua contaminata e diventare un veicolo per il batterio. È importante lavare accuratamente frutta e verdura con acqua e bicarbonato o utilizzare soluzioni disinfettanti specifiche per uso alimentare. Quando possibile, preferire la cottura delle verdure per eliminare eventuali microrganismi dannosi.
I frutti di mare crudi o poco cotti devono essere assolutamente evitati. Ostriche, cozze, vongole e altri molluschi possono accumulare batteri e tossine presenti nell’acqua in cui vivono, diventando un serio pericolo per chi soffre di un’infezione da Escherichia coli. Anche in questo caso, la cottura adeguata è essenziale per prevenire problemi digestivi e ulteriori complicazioni.
Un altro gruppo di alimenti problematici è rappresentato dagli zuccheri raffinati e dagli alimenti altamente processati. Dolci, biscotti industriali, snack confezionati e bevande zuccherate possono alimentare la proliferazione batterica nell’intestino, rallentando il processo di guarigione. Inoltre, questi cibi possono aumentare l’infiammazione e peggiorare la diarrea, portando a una maggiore disidratazione e debolezza fisica.
Anche le bevande gassate e l’alcol devono essere eliminate durante il periodo di recupero. Le bibite gassate possono irritare ulteriormente l’intestino già infiammato, mentre l’alcol può interferire con la risposta immunitaria e compromettere la capacità del corpo di combattere l’infezione. È preferibile bere acqua naturale, tè leggero o tisane senza zucchero per mantenere una corretta idratazione.
Un altro aspetto importante riguarda la gestione della dieta dopo l’infezione. Anche quando i sintomi iniziano a migliorare, il sistema digestivo rimane sensibile per alcuni giorni ed è fondamentale reintrodurre gli alimenti in modo graduale, iniziando con cibi leggeri e facilmente digeribili. Preferire brodi vegetali, carni bianche ben cotte, yogurt con fermenti lattici vivi e piccole quantità di verdure cotte può aiutare l’intestino a riprendersi senza subire ulteriori stress.
Seguire queste precauzioni alimentari non solo accelererà il recupero, ma ridurrà anche il rischio di recidive e complicazioni.